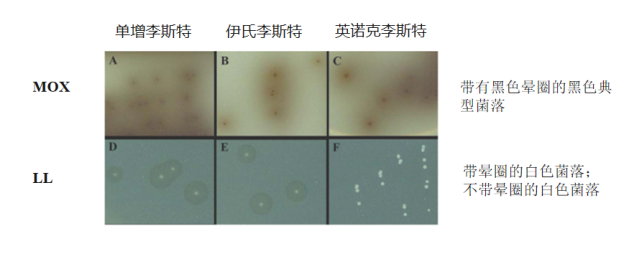
image.png

用于分離單核細(xì)胞增生李斯特菌的新型選擇性培養(yǎng)基
2024-01-31 11:33:41
革蘭氏陽性食源性致病菌--單核增生李斯特菌是世界范圍內(nèi)一個(gè)重要的公共衛(wèi)生和食品安全問題。孕婦、嬰兒、老年人和免疫抑制個(gè)體感染這種致病菌可導(dǎo)致嚴(yán)重的疾病和相對較高的死亡率。感染途徑與奶酪、肉類、牛奶、蔬菜和魚等食物有關(guān)。因此,從各種食品中分離單核增生李斯特菌的有效方法對保證食品的質(zhì)量和安全具有重要意義。
因此推薦這篇文章給大家,希望能對大家有所幫助。
Development of a Novel Selective and Differential Medium for the Isolation of Listeria monocytogenes

內(nèi)容
摘要
認(rèn)識(shí)到目前使用的選擇性培養(yǎng)基局限性,作者希望在保持成本效益的同時(shí),開發(fā)一種能提高特異性的替代培養(yǎng)基。本研究的目的是開發(fā)一種新的選擇性和特異性培養(yǎng)基來檢測單核增生李斯特菌(含卵磷脂和左氧氟沙星培養(yǎng)基-LL培養(yǎng)基)。通過分別采用純培養(yǎng)物和食品樣品進(jìn)行試驗(yàn),并與常規(guī)MOX培養(yǎng)基和兩種顯色培養(yǎng)基比較其特異性和靈敏度。
結(jié)果與討論
試驗(yàn)細(xì)菌在含有不同濃度左氧氟沙星的基礎(chǔ)培養(yǎng)基上的生長
為了確定抗生素的最佳濃度,作者測試了細(xì)菌在含有四種不同濃度左氧氟沙星的基礎(chǔ)培養(yǎng)基上的生長情況。在制備的基礎(chǔ)培養(yǎng)基中添加左氧氟沙星(濃度為:0.10mg/L、0.15mg/L、0.20mg/L、0.25mg/L)。


單核細(xì)胞增生李斯特菌在MOX培養(yǎng)基和LL培養(yǎng)基上回收情況
LL培養(yǎng)基上的細(xì)菌計(jì)數(shù)與MOX培養(yǎng)基上的細(xì)菌計(jì)數(shù)差異無統(tǒng)計(jì)學(xué)意義(P > 0.05)。在MOX和LL培養(yǎng)基上,培養(yǎng)24小時(shí)后菌落并不總是具有典型外觀。在48小時(shí),所有單核細(xì)胞增生李斯特菌菌株在這些培養(yǎng)基上形成正確的形態(tài)(分別為黑色帶黑色暈圈和白色帶暈圈)。
LL培養(yǎng)基的性能評價(jià)
所有測試的單核細(xì)胞增生李斯特菌菌株在每種測試培養(yǎng)基上產(chǎn)生典型的單核細(xì)胞增生李斯特菌菌落。.Brillience李斯特瓊脂和LL培養(yǎng)基的排他性最好。

使用加標(biāo)和未加標(biāo)食物樣本評估LL培養(yǎng)基的特異性和敏感性
Table 3 介紹了未加標(biāo)食物樣本的細(xì)菌學(xué)分析結(jié)果。陰性樣本的數(shù)量等于食物樣本總數(shù),Brilliance李斯特瓊脂、李斯特菌顯色培養(yǎng)基和LL培養(yǎng)基的特異性分別為96.5%、94.5%和96.0%。除MOX培養(yǎng)基外,LL培養(yǎng)基和兩種顯色特異性無顯著差異

Table 4表示,在50份加標(biāo)食品樣品中,李斯特顯色培養(yǎng)基和LL培養(yǎng)基的靈敏度最高,其次是Brilliance李斯特菌(92.0%)和MOX(54.0%)。

討論
美國FDA推薦的從食品中分離單核細(xì)胞增生李斯特菌的方法,樣品在李斯特增菌緩沖肉湯中進(jìn)行選擇性前增菌培養(yǎng),然后在選擇性和差異培養(yǎng)基(如PALCAM、Ox- ford、MOX和李斯特顯色培養(yǎng)基)上進(jìn)行平板培養(yǎng)。但是,檢測李斯特菌屬利用的七葉皂苷酶活性(如:PALCAM、牛津瓊脂和MOX),無法區(qū)分單核細(xì)胞增生李斯特菌與其他李斯特菌屬。此外,幾種使用有色化合物的顯色介質(zhì),如5-溴-4-氯-3-吲哚氧基-β-D-吡喃葡萄糖苷和L-α-磷脂酰肌醇,價(jià)格昂貴。使用顯色培養(yǎng)基檢測單核細(xì)胞增生李斯特菌通常涉及由李斯特菌屬產(chǎn)生的β-D-葡萄糖苷酶裂解底物5-溴-4-氯-3-吲哚氧基-β-D-吡喃葡萄糖苷,結(jié)合L-α-磷脂酰肌醇用于檢測磷脂酰肌醇特異性磷脂酶C (PI-PLC)和磷脂酰膽堿特異性磷脂酶C (PC-PLC)。
Oxoid chromogenic Listeria agar (OCLA)含有大豆卵磷脂而不是磷脂酰肌醇,用于區(qū)分單核細(xì)胞增生李斯特菌與其他李斯特菌屬。結(jié)果表明,大豆卵磷脂是磷脂酰肌醇的合適替代品。大豆卵磷脂是一種廉價(jià)且易得的產(chǎn)品,可用于檢測PI-PLC和PC-PLC的活性。本研究中,LL培養(yǎng)基含有大豆卵磷脂,用于區(qū)分單核細(xì)胞增生李斯特菌與其他李斯特菌。LL培養(yǎng)基具有更高的特異性和敏感性。與選擇性培養(yǎng)基比較,更好的區(qū)分單增李斯特菌與伊氏李斯特、英諾克李斯特。與顯色培養(yǎng)基比較,除價(jià)格優(yōu)勢外,LL培養(yǎng)基還能抑制PI-PLC和PC-PLC陽性細(xì)菌如蠟樣芽胞桿菌和葡萄球菌的生長。
綜合以上數(shù)據(jù)可知,本研究中的LL培養(yǎng)基比MOX具有更高的特異性和敏感性。尤其,LL可輕松區(qū)分單核細(xì)胞增生性李斯特菌、伊氏李斯特和英諾克李斯特,后者在常規(guī)PALCAM、牛津瓊脂和MOX上經(jīng)常產(chǎn)生假陽性結(jié)果。此外,LL培養(yǎng)基對Brilliance瓊脂和科瑪嘉表現(xiàn)出相似的特異性和敏感性,且成本降低。LL培養(yǎng)基還能抑制PI-PLC和PC-PLC陽性細(xì)菌如蠟樣芽胞桿菌和葡萄球菌的生長,這些菌在一些顯色培養(yǎng)基上引起假陽性。由于LL培養(yǎng)基的良好特異性,可減少對菌落進(jìn)行一步確認(rèn)試驗(yàn)的工作和時(shí)間。LL培養(yǎng)基的成本效益將使其適合常規(guī)實(shí)驗(yàn)室使用。雖然需要進(jìn)一步的研究來評估更多李斯特菌在LL培養(yǎng)基上的生長情況,但LL培養(yǎng)基可能為食品中單核增生李斯特菌的檢測提供了一種有價(jià)值的選擇性培養(yǎng)基。


0513-85596088





